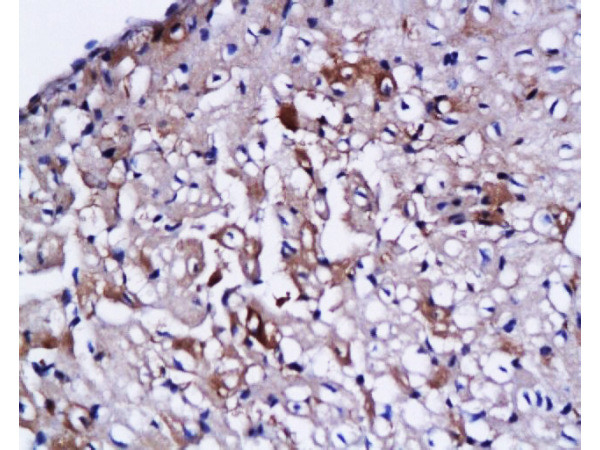
cardiac Troponin I Antibody in Immunohistochemistry (Paraffin) (IHC (P))

Search
Bioss
cardiac Troponin I Polyclonal Antibody
{{$productOrderCtrl.translations['antibody.pdp.commerceCard.promotion.promotions']}}
{{$productOrderCtrl.translations['antibody.pdp.commerceCard.promotion.viewpromo']}}
{{$productOrderCtrl.translations['antibody.pdp.commerceCard.promotion.promocode']}}: {{promo.promoCode}} {{promo.promoTitle}} {{promo.promoDescription}}. {{$productOrderCtrl.translations['antibody.pdp.commerceCard.promotion.learnmore']}}
产品信息
BS-0799R
种属反应
宿主/亚型
分类
类型
抗原
偶联物
形式
浓度
纯化类型
保存液
内含物
保存条件
运输条件
靶标信息
Cardiac Troponin I (Cardiac-specific troponin I, TnI, Troponin I) is an integral inhibitory protein in cardiac muscle that exists as part of a complex with troponin C (TnC) and troponin T (TnT). The TnT subunit of troponin binds to tropomyosin-t form, a troponin-tropomyosin complex, anchored in place by the binding of TnI to actin, within muscle thin filaments. Structural change resulting from the binding of calcium to specific sites on the regulatory TnC subunit, releases the inhibitory region of TnI from actin, anabling the attachment of the molecular motor protein myosin, allowing for muscle contraction and hence movement. The measurements of blood TnI and TnT levels is an important diagnostics indicator of heart muscle damage, and can be used to differentiate between angina and myocardial infarction in patients with chest pains. Cardiac Troponin I has also been shown to inhibit angiogenesis in vivo and in vitro. Mutations in the Cardiac Troponin I gene cause familial hypertrophic cardiomyopathy type 7 (CMH7) and familial restrictive cardiomyopathy (RCM).
仅用于科研。不用于诊断过程。未经明确授权不得转售。
篇参考文献 (0)
生物信息学
蛋白别名: Cardiac troponin I; cardiomyopathy, dilated 2A (autosomal recessive); MGC116817; Tpn1; troponin 1, type 3; troponin I type 3 (cardiac); Troponin I, cardiac muscle
基因别名: CMD1FF; CMD2A; CMH7; Ctni; RCM1; Tn1; TnI; TNNC1; TNNI3
UniProt ID: (Human) P19429, (Rat) P23693, (Mouse) P48787
Entrez Gene ID: (Human) 7137, (Rat) 29248, (Mouse) 21954